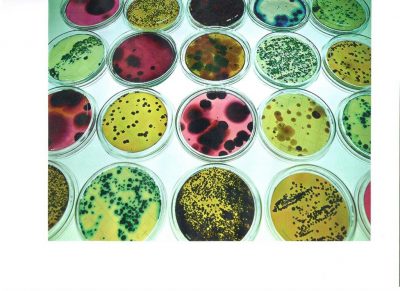
28- Colour, size and shape in bacterial diversity

Colour , size and shape in bacterial diversity
Publicada el 8/03/2026
Título: Colour , size and shape in bacterial diversity
Autor: Alejandro Jiménez Gómez
Dpto. Microbiología y Genética. Universidad de Salamanca
Descripción: Contact plates Rodac /Replicate Organism Detection And Counting) are a special type of Petri disher. They are used for microbiological control.